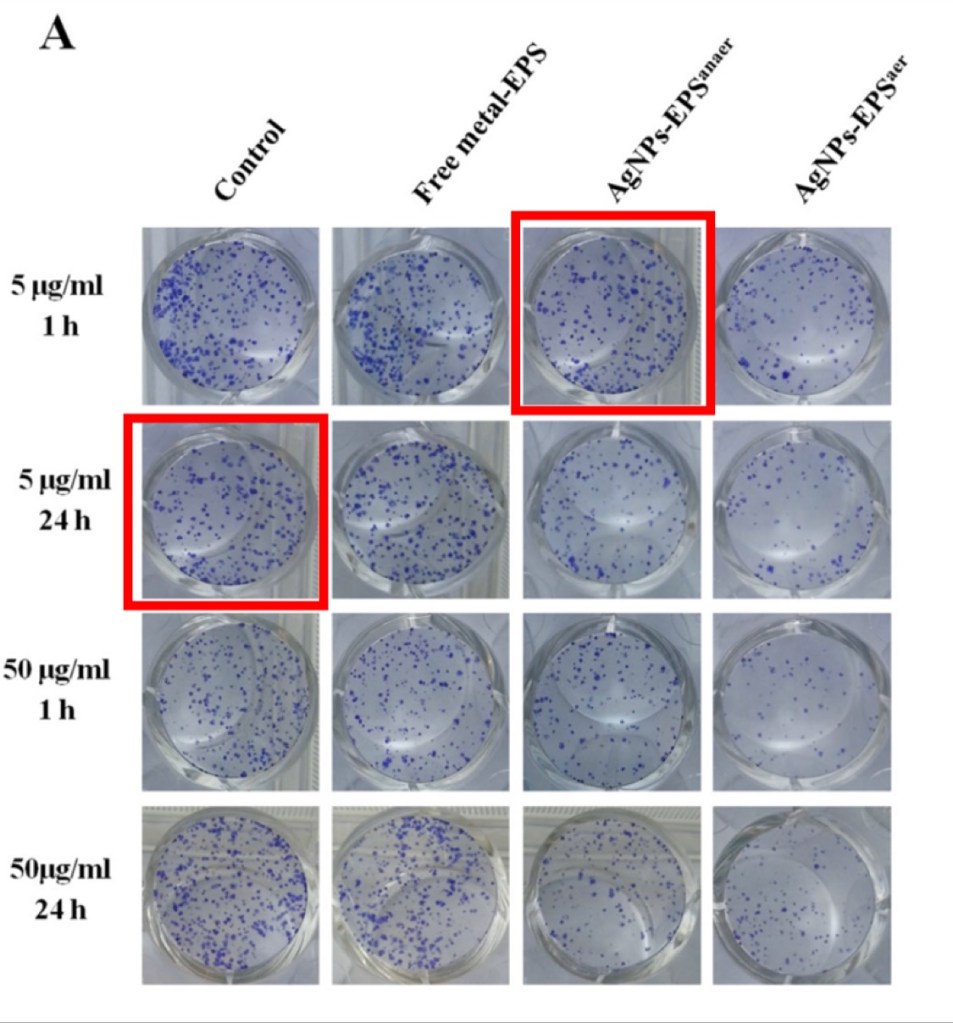

This post is not an accusation of misconduct.
In a previous post, I wrote about the high percentage of image concerns in papers published in Oncotarget, an Open Access journal. PubPeer, the post-publication peer review website contains many posts about Oncotarget papers flagged by me and other image duplication detectives.
Instead of reflecting on these concerns and improving their peer review and quality control process, Oncotarget apparently has decided to try to prove that these concerns are not real.
Three Oncotarget papers of concern
It appears that the journal hired an outside company to perform image forensics analysis on figures that had been flagged in three separate PubPeer posts. Let’s take a look at these three figures first and see if you would agree that the areas marked with boxes of the same color appear to show the same tissue or the same colonies.

Image Forensics Report “OT 1704” found no Manipulation.

Image Forensics Report “OT 8031” found no manipulation.
Image Forensics Report “OT 32549” found no manipulation.
It seems clear that the areas boxed with rectangles of the same color look very, very similar. One could even argue that they appear to be identical.
Oncotarget’s Forensic Analysis
Today, Oncotarget’s Editorial Office responded to these three PubPeer posts, saying in each case that “no manipulation was detected”. All three posts had a similar message:
The journal submitted the source file for this figure to image forensics analysis. We’ve included this image here, though unfortunately this file had to be compressed due to size limitations for uploads on PubPeer. We’ve also included the results of the image forensics analysis, performed by an outside party. The number in the top-right corner of the report correspond’s to the article’s original manuscript number. As you can see in the report, no manipulation was detected in this image.”
Oncotarget Editorial Office, PubPeer

No manipulations – but how about similarities?
You could argue that the forensics report is not wrong. In all three images shown above, the photos do not appear to be manipulated.
But that is not what the concern was. The concern in all three cases was that the images appeared to show an overlap, or that they might be identical. The image forensics reports, however, do not address whether the marked panels appear to show an overlap. It just says that the figures were not manipulated. It would be like calling a plumber to check on a leak in the kitchen sink and hearing that the house is not on fire. Or, calling 911 after detecting a fire in the kitchen, and having the firefighters tell you that the sink is not leaking. That is great to know, but not the problem you were hoping to solve.

It is very strange that the image forensic reports do not address similarities between the panels. In fact, all the reports from image forensics companies I have seen always analyze similarities between panels, since manipulation is much harder to detect in PDF-flattened images. So it is weird that these reports presented by Oncotarget only include manipulation analysis, not similarity analysis.
One could therefore wonder if the forensics reports were created by a really low-quality image forensics company. One could even wonder if they were really created by an independent outside party, and/or if similarity analysis results were left out on purpose. If that were the case, it is very sad and unethical that Oncotarget would resort to such practices to respond to image concerns. It would have been better to put their energy into improving the quality of their peer review, and to correct or retract the papers that have been flagged on PubPeer.
List of Oncotarget papers with forensic reports
List might be updated if more cases appear on PubPeer.
Jing Zhao et al. – Two hits are better than one: synergistic anticancer activity of α-helical peptides and doxorubicin/epirubicin – Oncotarget (2015) – doi: 10.18632/oncotarget.2754 – PubPeer: https://pubpeer.com/publications/B7DA3EA5C65E4EA6C050A53F160F8B
Stefania Capasso et al. – Changes in autophagy, proteasome activity and metabolism to determine a specific signature for acute and chronic senescent mesenchymal stromal cells – Oncotarget (2015) – doi: 10.18632/oncotarget.6277 – PubPeer: https://pubpeer.com/publications/C74A8C7AA46F3D00D393675E20A0C6
Miriam Buttacavoli et al. – Anticancer activity of biogenerated silver nanoparticles: an integrated proteomic investigation – Oncotarget (2018) – doi: 10.18632/oncotarget.23859 – Pubpeer: https://pubpeer.com/publications/8A41FC56CED32DD58B3A6D7AA43B82


One thought on “No Manipulation Was Detected in This Image”